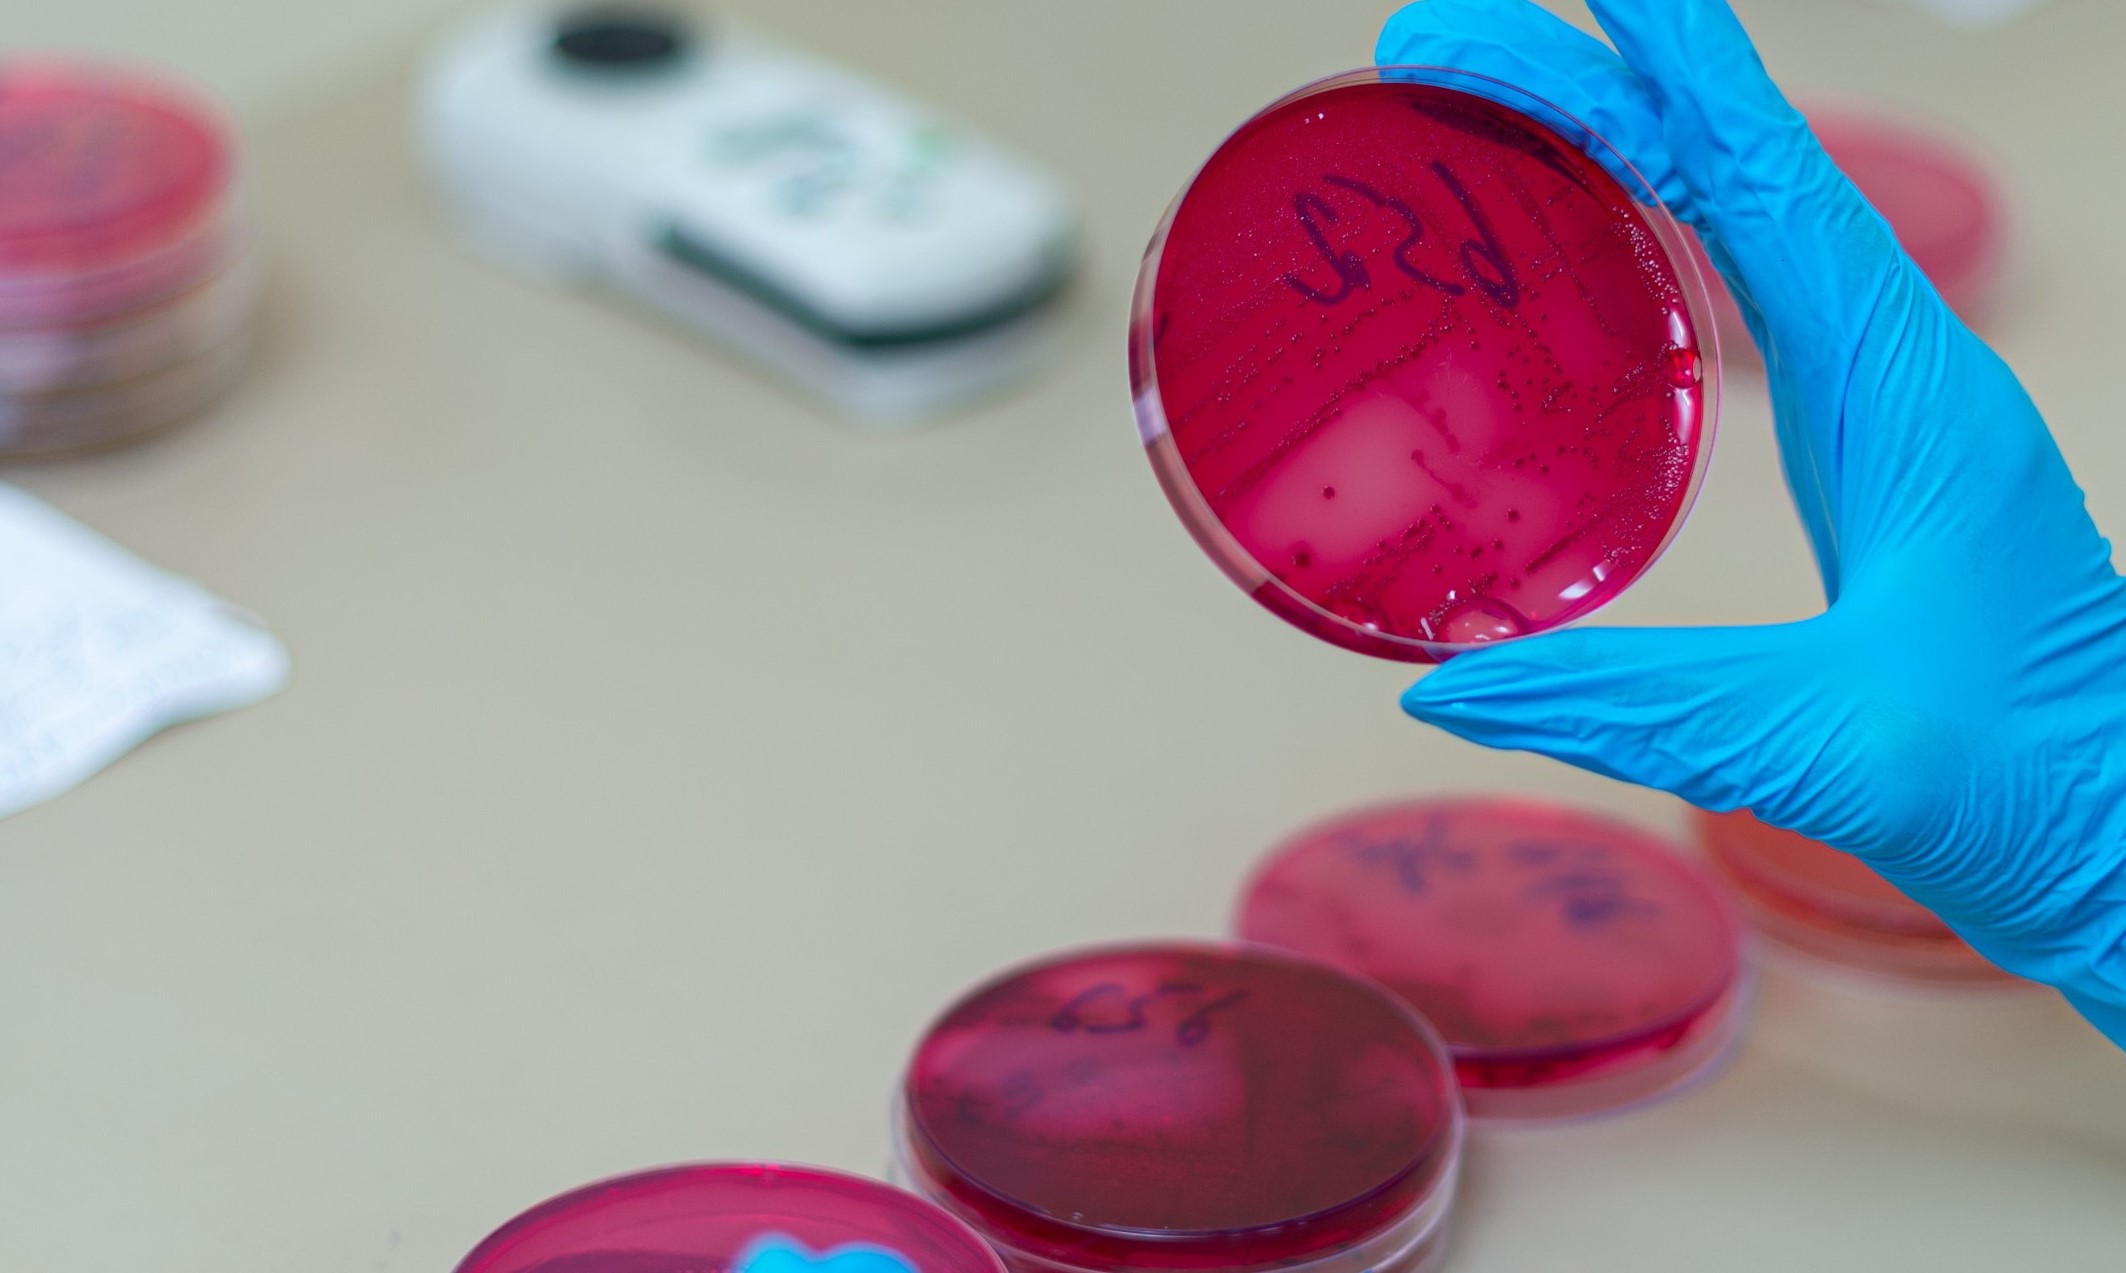

Մանրէաբանական լաբորատորիայում իրականացվում են հետևյալ հետազոտությունները.
- արյան ստերիլիության որոշում դասական մեթոդով և Bact/Alert 3D համակարգով
- արյան և մեզի մանրէաբանական հետազոտություն
- աղիքային վարակների հակածնային հետազոտություն
- այլ կենսանյութի մանրէաբանական հետազոտություն
- միկրօրգանիզմների նույնականացում դասական մեթոդներով և VITEK համակարգով:

 հայերեն
հայերեն
 English
English Русский
Русский